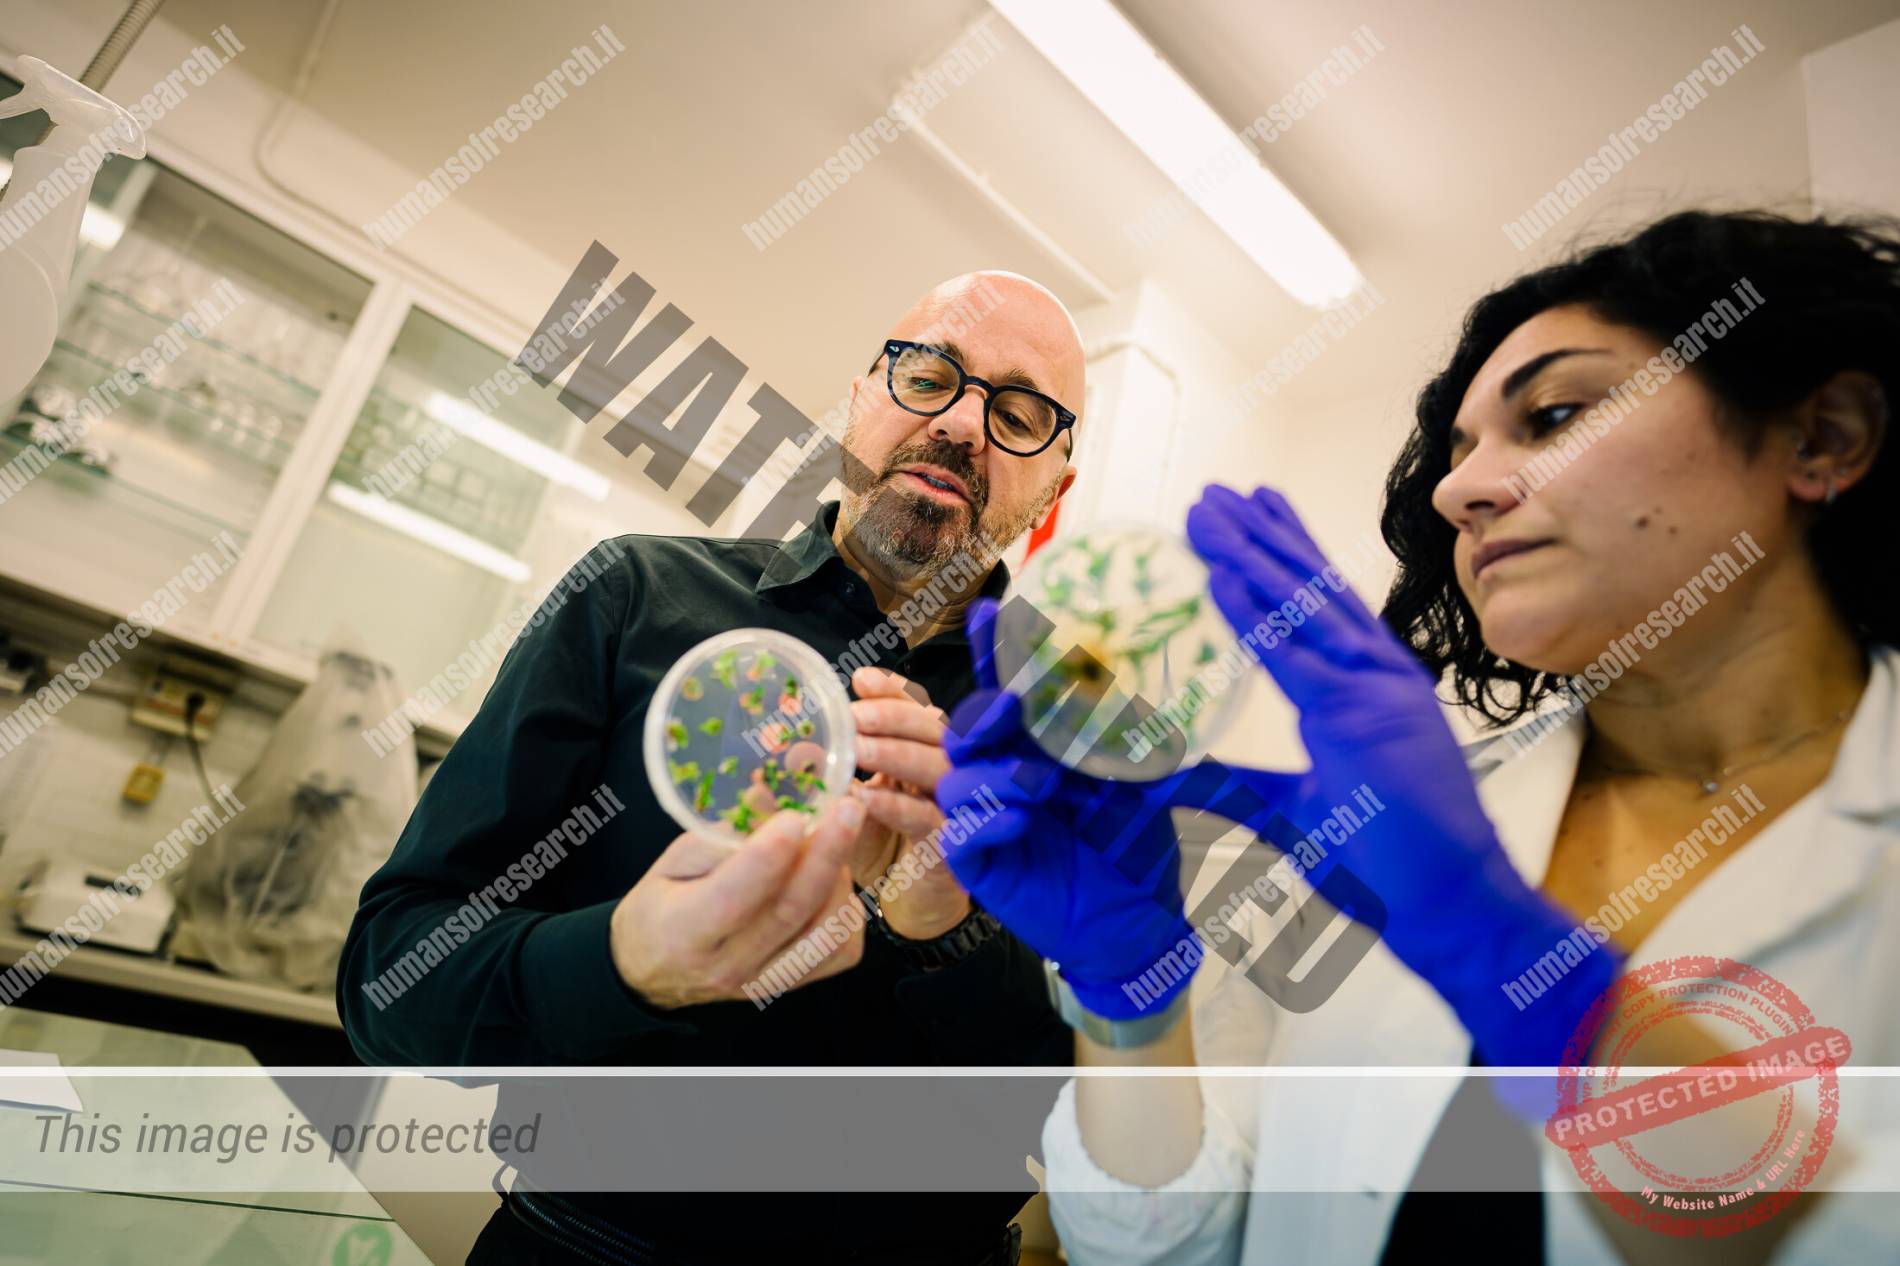
FOTO-2-4

Emidio Albertini
Professore ordinario di Genetica Agraria presso l'Università degli Studi di Perugia, dove ricopre il ruolo di delegato del Rettore per la Terza Missione, Innovazione Sociale, Relazioni con i Territori. È presidente della Fondazione POST (Perugia Officina della Scienza e della Tecnologia) e vicepresidente della Società Italiana di Genetica Agraria.
Il mio lavoro è accompagnare senza trattenere, lasciare spazio finché chi cammina accanto diventa più bravo. ![]()
La prima cosa che arriva è l’odore. È quello dell’olio caldo che sale dalla cucina, denso, avvolgente, mentre Emidio Albertini è concentrato su un gesto preciso, ripetuto, quasi meditativo. Le mani si muovono lente e sicure: snocciola le olive una a una, le farcisce e poi le richiude con cura. Sta preparando le olive ascolane. È un lavoro che richiede tempo, pazienza, attenzione. Non c’è fretta, e non sembra esserci nemmeno altrove.
Racconta che quelle olive gli ricordano le giornate passate a casa con i suoi genitori. Lo dice senza nostalgia ostentata, come si condividono certe cose mentre si cucina insieme. È un ricordo che passa dal corpo prima che dalle parole. E mentre lo ascolti viene naturale pensare che anche il suo modo di fare ricerca funzioni così: partire da qualcosa di semplice, rispettarne la forma, lavorarci con pazienza, accettare l’attesa.
A guardarlo cucinare, parlare, pensare, sembra sempre proiettato in avanti. Come se stesse già immaginando il prossimo progetto, la prossima idea, il prossimo passo. E invece spesso è il contrario. È uno che si ferma a guardare indietro. Non per rimpianto, ma per capire. Perché il passato, per lui, non è mai qualcosa da archiviare: è una bussola.

Uscire dalla gabbia
«Al me delle scuole superiori direi: vai via, esplora chi sei», dice. «Per anni ho vissuto in una gabbia in cui non potevo essere me stesso». È una frase che apre uno spazio più ampio. Racconta cosa volesse dire crescere sentendosi fuori posto, trattenuti, non del tutto liberi. Essere gay, in certi contesti e in certi anni, voleva dire imparare a misurarsi, a rimandare, a stare in silenzio. A volte il problema non è chi sei, ma quanto spazio hai per esserlo.
La California entra in questo racconto come una frattura netta. Lì, lontano da Perugia, Emidio sperimenta una libertà nuova, concreta, quotidiana. «Quello che offriva la California rispetto a quello che offriva Perugia era tutto un altro mondo». Non solo dal punto di vista scientifico, ma umano. Essere sé stessi senza doverlo spiegare. Senza doverlo difendere. In certi luoghi non devi spiegarti, semplicemente esisti. E questo cambia tutto.
Eppure, torna. Non senza conflitto. Non senza domande. Torna perché la vita, a volte, ti riporta dove non avevi previsto di restare. E lì costruisci. «Al me universitario direi: fai la ricerca», racconta, «perché è quello che poi ho fatto e che volevo fare». Non è una contraddizione: è una traiettoria fatta di andate e ritorni, di scelte che maturano col tempo.
La ricerca, per lui, resta una forma di esplorazione. «Fare il ricercatore per me è aver realizzato un desiderio che avevo fin da piccolo». Da ragazzo pensava di fare l’enologo. Poi altri sogni, la Bocconi, la comunicazione d’impresa. Ma qualcosa lo ha riportato a Perugia, quasi per caso. Agraria. La genetica. Un incontro inatteso che, lentamente, è diventato decisivo. «Mi sono innamorato della genetica e ho capito che quella era la strada che volevo davvero seguire». Per Emidio la ricerca non è mai stata un percorso ordinato. È sempre stata una prova. Come quella sera a cena in cui qualcuno sosteneva che fosse possibile estrarre DNA dalle opere d’arte. Nessuno ci credeva davvero. Lui sì. Anni dopo, da microframmenti della Madonna di Citerna attribuita a Donatello, il DNA ha raccontato una storia che nessun archivio poteva raccontare. «Era nata da una scommessa», dice, «e alla fine vedere il risultato è stata una soddisfazione enorme».
Emidio si occupa di genetica delle piante, ma più che applicare metodologie gli è sempre interessato stare nel punto in cui quelle metodologie nascono. In fondo, quello che lo ha sempre attratto è capire come le cose si generano, si trasformano e lasciano tracce: che siano semi, opere d’arte o relazioni umane.
Seguendolo in laboratorio si capisce però che, per lui, il punto non è mai solo il risultato.
È il percorso. È il modo in cui ci si arriva. È l’attenzione alle persone. Entra, osserva, si ferma, ascolta. Sa cosa stanno facendo tutti, ma soprattutto sa chi sono. I collaboratori non sono mai figure di sfondo.
Restare identici o cambiare
Lavora ancora oggi su un gene che, secondo lui, custodisce una parte cruciale della riproduzione delle piante: quei meccanismi invisibili che decidono se una pianta si riprodurrà sessualmente oppure se, attraverso l’apomissia, produrrà semi che sono copie di sé stessa. Una lotta evolutiva tra il restare identici e il cambiare, tra l’efficienza del clonarsi e il costo necessario della riproduzione sessuale. Il primo articolo lo ha pubblicato quasi vent’anni fa, eppure la domanda non si è esaurita. «Abbiamo investito molto tempo e denaro», racconta, «e ancora non abbiamo i risultati che ci aspettavamo, ma non ci siamo mai arresi».
È una ricerca che somiglia a un filo lungo, che attraversa gli anni. Racconta che si discute anche animatamente, ma che il giorno dopo è come se non fosse successo nulla. È il segno di un rapporto che regge. E quando la giornata finisce, spesso non finisce davvero. La sera ci si vede, si va a bere qualcosa insieme. Colleghi che diventano amici. La ricerca, in fondo, è un coro imperfetto, che regge anche quando una voce si incrina.
Ed è forse proprio lì, fuori dal laboratorio, quando la scienza smette di essere solo lavoro e diventa anche vita condivisa, che il nome cambia. Succede senza accordi, senza annunci. Qualcuno lo fa per primo, poi lo fanno tutti. Mimmo.
È il nome che usano gli amici, i collaboratori, chi lo frequenta davvero. Non è una confidenza cercata, è una confidenza che accade. Con lui le distanze si accorciano naturalmente.

Far crescere le persone
Essere mentore, per Mimmo, non significa formare persone a propria immagine e somiglianza. Sarebbe un errore. «Io spero sempre che chi lavora con me sia più bravo di me». Il suo compito è accompagnare, non plasmare. Lasciare spazio. Far crescere. «Non voglio perdere la parte più bella del mio lavoro, quella di far crescere le persone».
Questo sguardo attento alle persone attraversa anche il suo impegno sui diritti civili.
Mimmo parla spesso di soffitti di cristallo, e non solo di quelli più visibili. Accanto al divario di genere, ci sono quelli legati all’identità, all’orientamento, al benessere lavorativo. Da presidente del CUG e poi nei ruoli istituzionali, ha lavorato perché l’università diventasse un luogo più abitabile, più giusto. Perché nessuno debba più sentirsi in gabbia.
Lo stesso senso di responsabilità lo ha portato dentro la governance dell’Ateneo, come delegato del Rettore per il settore Terza Missione, Innovazione Sociale e Relazioni con i Territori all’Università degli Studi di Perugia. Non per ambizione personale, ma per coerenza. Se vedi qualcosa che non funziona, non puoi voltarti dall’altra parte. Devi provare a cambiarla. È lo stesso approccio che ha sempre avuto nella ricerca: non hai certezze, hai una direzione.
Accanto a questo c’è l’impegno nella comunicazione della scienza, come presidente del POST di Perugia. Rendere la ricerca accessibile, comprensibile, condivisa. E, come se non bastasse, nella sua giornata trova spazio anche per il quartiere, attraverso un’associazione che promuove eventi sociali e momenti di comunità. Un altro modo per stare nei posti, non solo attraversarli. A volte tutto questo pesa. Gli impegni si accumulano, il tempo per sé si riduce. «Mi manca un po’ la mia vita», ammette. Senza retorica. Con la lucidità di chi sa che prendersi cura degli altri richiede anche imparare a prendersi cura di sé.
Le olive ascolane, intanto, sono pronte. Croccanti fuori, morbide dentro. Un equilibrio delicato, come quello che Mimmo cerca ogni giorno tra passato e futuro, ricerca e relazioni, istituzioni e vita. Continuare a cercare, per lui, non è un obiettivo: è una posizione.
Seduti a tavola, è chiaro che questa non è solo una cena. È un modo di stare al mondo. Fatto di memoria, di cura, di scommesse che vale sempre la pena tentare. E soprattutto di persone da tenere vicine.












